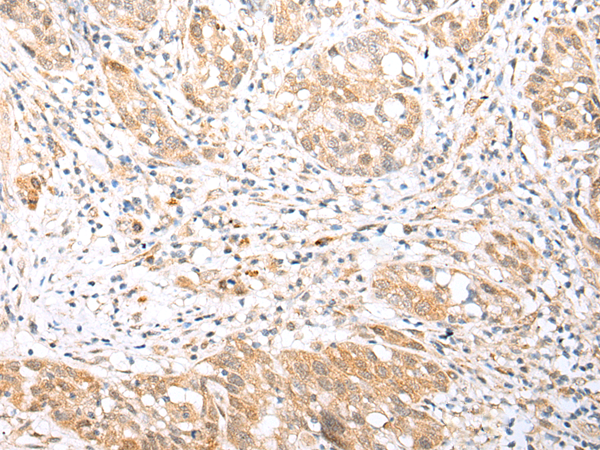
一抗

中文名稱:兔抗BCL2L12多克隆抗體
|
Background: |
This gene encodes a member of a family of proteins containing a Bcl-2 homology domain 2 (BH2). The encoded protein is an anti-apoptotic factor that acts as an inhibitor of caspases 3 and 7 in the cytoplasm. In the nucleus, it binds to the p53 tumor suppressor protein, preventing its association with target genes. Overexpression of this gene has been detected in a number of different cancers. There is a pseudogene for this gene on chromosome 3. Alternative splicing results in multiple transcript variants |
|
Applications: |
ELISA, IHC |
|
Name of antibody: |
BCL2L12 |
|
Immunogen: |
Fusion protein of human BCL2L12 |
|
Full name: |
BCL2-like 12 (proline rich) |
|
SwissProt: |
Q9HB09 |
|
ELISA Recommended dilution: |
1000-2000 |
|
IHC positive control: |
Human thyroid cancer and human gastric cancer |
|
IHC Recommend dilution: |
25-100 |


 購(gòu)物車(chē)
購(gòu)物車(chē) 幫助
幫助
 021-54845833/15800441009
021-54845833/15800441009